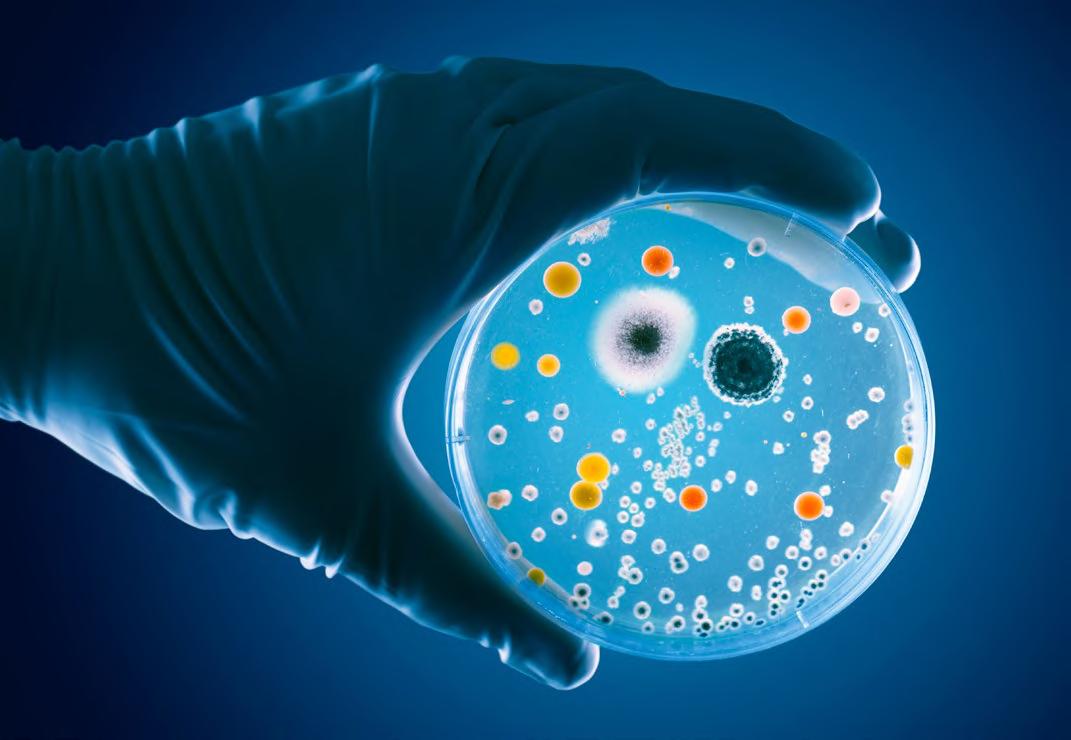

Directora General: Ing. Celeste Leoz de Ribeiro Coordinación General: Lic. Viviana Miranda
Coordinación de Contenido: Jazmín Fernández
Diseño y Diagramación: Andrea Gavilán
Redacción y Edición: Adri Morro Prensa + Contenidos Comercial: marketing2@smm.com.py

Fotos: Guillermo Ortíz, colaboradores, banco de imágenes del Sanatorio MIGONE y ShutterStock.
MIGONE News es una revista de distribución gratuita de SERVICIOS MÉDICOS MIGONE; producida, editada, diseñada y diagramada por el Departamento de Marketing y Comunicación de la empresa.

Colaboradores:
Lic. Liz Coronel
Lic. Guadalupe Barriocanal
Dr. Omar Santacruz
Dra. Amaya Ortíz
Dra. Leticia Gutiérrez Ferrari
Lic. Jazmín Pérez
Dra. Cinthia Pérez Ortíz
Dra. Mónica Valdez Campuzano
Lic. Almudena Cino Blanes
Dra. Mirtha Talavera
Dra. Clara Moreno
Lic. Nathalia Harasymowycz
Servicios Médicos Migone
Sanatorio Migone Battilana
Tel.: (021) 218-2000
Clínica Villa Morra
Tel.: (021) 218-2700
Prohibida su reproducción parcial o total sin previa autorización del Sanatorio MIGONE. La información y las fotos de los artículos y las secciones enviadas por los colaboradores son responsabilidad de estos.
Año 14 · Nº 79 · setiembre de 2023
04
38
SUMARIO
STAFF - REVISTA MIGONE NEWS
18 MICROBIOTA INTESTINAL 22 HIPERTENSIÓN ARTERIAL EN NIÑOS Y ADOLESCENTES 26 REHABILITACIÓN CARDIOVASCULAR 30 ¿QUÉ ES LA RINITIS ALÉRGICA? 34 PUBERTAD PRECOZ 38 LOS TRASTORNOS DE LA COMUNICACIÓN EN NIÑOS DE 3 A 5 AÑOS 42 LACTANCIA MATERNA: RESPONSABILIDAD DE TODOS 46 DONA SANGRE, DONA PLASMA, COMPARTE LA VIDA, COMPÁRTELA CONSTANTEMENTE 14 GRIPE MAL CURADA 10 DIETA ANTIINFLAMATORIA Y FATIGA 6 AGOSTO, MES DE LA OBSTETRICIA Escaneá el código QR para acceder a las Revistas Digitales

Agosto, mes de la obstetricia
El 31 de agosto conmemoramos el Día Nacional y Latinoamericano de la Obstetricia. Año tras año, en agosto se reconoce el invalorable aporte de los obstetras a la salud de la población.
¿Cuál es el papel del obstetra? El obstetra se desempeña en diversas áreas de un servicio de salud, acompaña distintos ciclos de la mujer, desde la adolescencia, la etapa preconcepcional, prenatal, parto y puerperio, promoviendo la salud de la mujer y los hábitos de prevención de enfermedades.


La Organización Mundial de la Salud (OMS), organismos internacionales e innumerables investigaciones han concluido que los obstetras son claves para reducir el número de muertes maternas y discapacidades de madres y recién nacidos.

06 OBSTETRICIA
Lic. Liz Coronel Obstetra
Sin embargo, el obstetra no sólo se ocupa de la salud física de la madre y del bebé, sino que además cuida los factores psicológicos y sociales vinculados a este periodo tan especial de la maternidad, por lo que su calidad humana es tan importante como la profesional.

Apoyo durante la gestación, parto y puerperio
Contemplando algunos de los ejes fundamentales de esta profesión se destacan los valores que el obstetra brinda en el apoyo durante la gestación, parto y puerperio. Así pues, durante la gestación, acompaña a la mujer a conocer el proceso fisiológico del embarazo y le ayuda con asesorías educativas que le permiten conectar con su cuerpo, con su bebé y obtener herramientas para lograr la mejor de las experiencias. Asimismo, ayuda a la mujer a despertar su conciencia corporal, lo cual le permite modificar la respuesta ante todos los cambios que
se producen durante la gestación y que hasta podrían llegar a influir en la calidad de vida y bienestar de la madre.
La palabra obstetricia proviene del latín “obstare”, que significa estar a la espera, describe a la perfección la función del obstetra durante el proceso del parto, quien debe:
• Esperar.
• Observar desde lejos.
• Controlar las contracciones, escuchar si los latidos del bebé son normales, hacer tactos vaginales para saber cómo avanza la dilatación.

• Ofrecer alivio físico cuando la ola de contracciones se vuelve más y más fuerte.
• Mantenerse la mayor parte del tiempo en silencio y hablar cuando sea necesario.
• Recordar a la mujer que es capaz de lograrlo.
OBSTETRICIA


El obstetra no hace partos, se dedica a acompañar los nacimientos. Brinda la contención necesaria para lograr un parto libre, consciente y amoroso.
Acompañamiento durante el nacimiento
El nacimiento es un momento muy vulnerable para la mujer, así como muy estresante. Está comprobado que el acompañamiento durante el nacimiento reduce el estrés y la ansiedad de la madre. Es importante fomentar la presencia de la pareja para brindar apoyo físico, ofrecer todas las medidas que mejoran el bienestar y la comodidad, ayudar a la mamá a caminar, ir al baño o, a veces, simplemente estar. Igualmente, brindarle apoyo emocional, comprensión y presencia durante el parto, manteniendo una actitud empática, serena, comprensiva y motivadora.
Asimismo, es posible contribuir a que la madre logre una cesárea humanizada que se refiere a una cesárea necesaria en la que la madre ha participado en la toma de decisiones y se han respetado sus necesidades físicas y emocionales. Las preferencias de la madre se tienen en cuenta y ciertos elementos del parto natural se mantienen.
Cuidar dos vidas simultáneas no es tarea fácil, pero es el mayor honor.
El obstetra y el apoyo a la lactancia materna
Luego del nacimiento, el obstetra y la madre se unen al desafío de la lactancia materna. Es muy importante recordar estos puntos para favorecer la lactancia materna exitosa.
1. Está en manos del obstetra brindar información sobre los beneficios de la lactancia materna, las técnicas de adecuadas y cómo solucionar posibles desafíos contribuyendo a aumentar la confianza y el conocimiento de la madre.
2. Recalcar a la madre y entorno la importancia del apoyo emocional de la pareja, la familia y los amigos cercanos. Esto es fundamental para una experiencia positiva de lactancia. El apoyo alienta y fortalece a la madre durante los desafíos que pueda enfrentar, además puede hacer sentir a la mamá más segura y confiada.
3.mComenzar la lactancia en las primeras horas después del nacimiento del bebé puede facilitar el establecimiento de una buena succión y producción de leche.
4. Alimentar al bebé a demanda: responder a las señales de hambre del bebé y alimentarlo a demanda en lugar de seguir horarios estrictos. Esto ayuda a establecer una producción de leche adecuada y una relación de lactancia saludable. La leche materna es el alimento más perfecto, completo y especialmente diseñado por la naturaleza para nutrir al lactante.
5. Realizar contacto piel con piel entre la madre y el bebé, especialmente en las primeras horas y días después del nacimiento, favorece el apego y la conexión, lo que puede facilitar la lactancia.

6. La lactancia materna es un trabajo en equipo de todo el entorno familiar desde el inicio hasta que se decida destetar. El papá tiene un rol fundamental porque es el apoyo incondicional.
Es importante tener en cuenta que cada mujer y bebé son únicos, y pueden surgir diferentes desafíos en la lactancia. Es allí donde el obstetra tiene un papel sumamente importante como profesional, brindando la información necesaria sobre posturas correctas para lograr un buen agarre, y permitiendo a la madre y al recién nacido decidir cuál es la mejor opción para ellos. La experiencia de la maternidad produce un cambio profundo en la mujer y se presentan muchos sentimientos intensos y contradictorios que, a veces, las desbordan. Como profesionales capacitados presentes en este evento tan importante en sus vidas, los obstetras tenemos la responsabilidad de combatir todo mito o concepto erróneo, brindando información certificada, contribuyendo así a empoderar a las mujeres en el camino de la maternidad.
08
Tengamos siempre presente que no sólo ha nacido un bebé, también ha nacido una mamá.

Dieta antiinflamatoria y fatiga

Vivimos en un medioambiente con disponibilidad alimentaria constante, con exceso de estrés sostenido durante todo el día, sin la capacidad de resolverlo. No podemos ser ajenos a que existen factores nutricionales que pueden estar influyendo como disparadores o perpetuadores de la fatiga, como lo son los inadecuados hábitos de vida, algunos de ellos son el aporte inadecuado de calorías por mucho tiempo, la alimentación proinflamatoria crónica, el exceso de estimulantes y alcohol, la deshidratación, la deficiencia de micronutrientes y antioxidantes, y los picos y bajones de glucosa frecuentes.
¿Cómo es una alimentación inflamatoria?

Es aquella que se caracteriza por ser pobre en micronutrientes y antioxidantes. Generan alta carga de toxinas a nivel hepático, favorecen al aumento de glucosa en sangre y a la dislipidemia (colesterol y triglicéridos altos en sangre).
La alimentación inflamatoria en personas con fatiga la cronifica o incluso, a veces, la ocasiona. Se trata de un exceso crónico de alimentos procesados, carbohidratos refinados, aditivos, colorantes, edulcorantes artificiales, alcohol, cafeína, descuidando los horarios y las dosis, exceso

10 NUTRICIÓN
Lic. Guadalupe Barriocanal Nutricionista
de proteínas o exceso calórico crónico; alimentos que ocasionen sensibilidad, intolerancia o alergia, por ejemplo, el gluten o los lácteos.

Además, el exceso de alimentos chamuscados, tostados y asados, como esa famosa costrita quemada del asado —que contiene y produce altas cantidades de sustancias cancerígenas como los hidrocarburos aromáticos policíclicos—. De manera similar, un consumo elevado de grasas inflamatorias, como el exceso de omega 6, grasas refinadas, grasas trans y grasas oxidadas, junto con un bajo aporte de omega 3.
Algunos ejemplos de grasas inflamatorias
-mMargarina o aceite vegetal hidrogenado.
-mAceite de maíz, aceite de girasol, de soja, de canola.
-mConsumo de frituras en estos aceites.
“Es importante recalcar que los alimentos inflamatorios o refinados, lejos de aportar nutrientes, nos desnutren, porque utilizan la poca cantidad de nutrientes que tenemos en nuestro cuerpo para metabolizarse. Entonces, nos van dejando desprovistos de los nutrientes sanos.”
Alimentación antiinflamatoria y fatiga
Una alimentación antiinflamatoria se caracteriza por ser una dieta balanceada, alta en granos enteros, fibras, vegetales ricos en polifenoles (verduras, frutas, cacao, cúrcuma, especias, té verde) y alimentos ricos en ácidos grasos omega 3, que tiene como principal beneficio mejorar los síntomas de fatiga.

11
NUTRICIÓN
La pirámide antiinflamatoria es una guía de alimentos que se caracteriza por ser preponderante en vegetales (crudos o cocidos). Incluye proteínas y grasas de calidad, así como granos, legumbres, frutas y almidones no refinados. Asimismo, comprende especias con efectos antiinflamatorios, antioxidantes, antimicrobianos y suficiente agua.

El método del plato en una alimentación antiinflamatoria se distingue por ser 75 % verduras y 25 % proteínas de origen animal o vegetal con agregado de grasas de calidad.
Dieta mediterránea
Varios estudios demuestran que la dieta mediterránea reduce los niveles de fatiga percibidos en pacientes que cambiaron la carne roja por pescados, y los cereales refinados por cereales integrales.
En la dieta antiinflamatoria, se prioriza una alimentación mediterránea alta en polifenoles, micronutrientes y antioxidantes, los cuales se encuentran en frutas, verduras, legumbres, frutos secos y semillas. De igual manera, se incluyen el omega 3 presente en pescados y aceite de oliva, así como alimentos naturales y orgánicos como frutas y verduras, debido a la fibra y los nutrientes que contienen. Esto mejorará, a corto plazo, la microbiota intestinal y ayudará al correcto funcionamiento del intestino y del sistema inmune. Por ende, es importante evitar una alimentación con alimentos ultraprocesados, un consumo alto en carnes rojas, carbohidratos refinados y aditivos y edulcorantes artificiales. El consumo de estos alimentos deriva en un intestino permeable, disbiosis e inflamación, que lleva a síntomas como distensión abdominal, dolor, gases, estreñimiento, diarrea, cansancio, problemas de concentración.
Lineamientos para disipar la fatiga en nuestro día a día
- Exponerse al sol entre 10 a 15 minutos tres veces a la semana (antes
de las 10 de la mañana) para el aporte de vitamina D3.
- Consumir agua filtrada (para reducir la carga microbiana, metales pesados y otras sustancias no deseadas).
- Incluir, como base de la alimentación, verduras y frutas de estación, con variedad de colores, siempre que puedan ser orgánicas, mejor.
- Consumir tubérculos y raíces (papa, mandioca, batata).
- Consumir cereales y legumbres integrales sin refinar.
- Asegurarse de que cada comida sea alta en grasas buenas, incluir alimentos como aceite de oliva virgen extra, aguacate, aceitunas, frutos secos (nueces, almendras, macadamias), semillas, manteca, ghee.
- Aportar proteína de alto valor biológico, como huevo, caldo de hueso (rico en minerales y gelatina o colágeno).
- Consumir carnes y aves con moderación (si son asadas, idealmente condimentar dos horas antes en la heladera con limón, ajo y hierbas aromáticas, pues reducen los pro-
ductos de glicación avanzada que se forman con la cocción y también tienen cierto poder antimicrobianos).
- Incluir pescados (omega 3).
- Reducir el gluten según el cuadro individual de cada persona, y si existe tolerancia al gluten, preferir panes de masa madre.
- Consumir quesos y yogures idealmente caseros y de animales de pastura, sin endulzantes ni aditivos.
- Incluir alimentos probióticos como kéfir, yogur, kombucha, chucrut, kimchi (que aportan bacterias beneficiosas para nuestro organismo).
- Preferir té verde, jengibre, cúrcuma, hojas aromáticas y especias.
- Incluir infusiones de hierbas, como manzanilla, anís y menta.
Micronutrientes y antioxidantes vitales para mejorar la fatiga
• Vitamina C
• Complejo B
• Adecuado aporte de sodio, magnesio, zinc, folato
• L-carnitina
• Triptófano para personas con disbiosis intestinal

12
Gráfico fuente: www.guerrasintestinas.com/alimentacion-antiinflamatoria/
• Omega 3
• Coenzima Q10
• Especias como Cúrcuma
• Jengibre
• Probióticos
También influyen los horarios de las comidas según composición: Cenar al menos 3 a 4 horas antes de dormir. Evitar carnes rojas de noche para un mejor descanso digestivo.

Tener en cuenta:
- Alto en proteínas y grasas: más de 4 horas
- Carne roja: aproximadamente 4 horas en el estómago
- Carnes blancas, legumbres: 3 horas
- Huevos, quesos: 2 horas
- Almidones: menos de 2 horas
- Frutas y verduras: 30 minutos a 1 hora
- Líquidos: menos de 2 horas

Conclusión
Para evitar la fatiga crónica debemos proveer a nuestro cuerpo la energía adecuada mediante una alimentación abundante en nutrientes. Que la dieta sea suficiente en carbohidratos (pero no en exceso) y fibras de bajo índice glucémico.

Que sea suficiente en proteínas y grasas antiinflamatorias. Evitar las grasas inflamatorias, como la margarina o aceite vegetal hidrogenado, aceite de maíz, aceite de girasol, de soja, de canola y consumo de frituras en estos aceites.
Cuidar siempre los niveles de hidratación. Suficiente ingesta de agua. Evitar alimentos ultraprocesados, refinados. Reducir al máximo la ingesta de alcohol, el uso de plásticos, aditivos, agrotóxicos. Consumir, siempre que se pueda, frutas y ver-
duras de origen orgánico. Evitar el exceso de cafeína, cuidando los horarios y las dosis.
Gripe mal curada
El término gripe mal curada es de uso popular y en realidad está relacionado con las complicaciones de enfermedades de las vías aéreas respiratorias o un mal diagnóstico.
Dr. Omar Santacruz Médico pediatra - neumólogo


El término gripe es posible asociar principalmente a dos eventos: el resfrío común y la enfermedad de la gripe. La gripe es causada por el virus de la influenza, suele ser estacional, en otoño e invierno, aunque se puede presentar en todos los meses del año.
El contagio se produce cuando se inhala las gotitas de Flügge que son pequeñas gotas que se expulsan de manera inadvertida por la boca o la nariz al hablar, estornudar, toser o espirar.

14 NEUMOLOGÍA
También se propaga por contacto mano a mano con alguien que esté enfermo, al compartir objetos contaminados, como utensilios de comida, toallas, juguetes o teléfonos. Si la persona se toca los ojos, la nariz o la boca después de dicho contacto, es probable que contraiga la enfermedad.

Los síntomas pueden aparecer a las 24 horas del contacto con la persona enferma y se manifiesta por una serie de síntomas, como fiebre alta de 39 grados o sensación febril con escalofríos, dolores musculares, cefalea o dolor de cabeza, dolor de garganta, estornudos, congestión nasal intensa, malestar general o no sentirse bien.
El resfrío común, en cambio, produce síntomas menos intensos, y muchos tipos de virus pueden ser sus cau-

santes. La secreción nasal, en ambos casos, puede empezar siendo clara y puede volverse más espesa y de color amarillento o verde a medida que sigue su curso. Esto no implica que haya una infección bacteriana asociada ni un empeoramiento de la enfermedad.
La tos al inicio seca, después catarral, puede persistir por un tiempo más prolongado, en especial en personas fumadoras o que inhalan dispositivos electrónicos o vapeadores. Los síntomas en general desaparecen entre los siete a diez días.
La gripe mal curada va asociada a complicaciones de la gripe o del resfrío común.
Las complicaciones las podemos separar en aquellas que afectan las vías aéreas superiores o inferiores. En caso de afectar las vías aéreas superiores, la complicación más frecuente es la sinusitis, seguida de las infecciones de oídos.
La sinusitis o rinosinusitis se presenta como nariz tapada o congestionada, secreción nasal espesa o por la parte posterior de la boca, reducción del sentido del olfato y del gusto, dolor de oído y de cabeza (más intensa al inclinar la cabeza para abajo), mal aliento y tos persistente.

Los factores de riego más comunes para padecer sinusitis son los pólipos nasales, desviación de tabique nasal, asma, sensibilidad a la aspirina, tumores, infección dental y personas fumadoras.


Si la gripe mal curada afecta las vías aéreas inferiores, hablamos de neumonías, bronquitis aguda, laringitis y asma.


16
NEUMOLOGÍA
Es importante el uso del tapabocas al concurrir a lugares de mucha afluencia, como hospitales u sanatorios, supermercados, shoppings, cines, eventos deportivos, colectivos, entre otros, en especial en los meses de otoño e invierno. Evitar la automedicación.

Microbiota intestinal

En los últimos años se ha avanzado mucho en el conocimiento de la microbiota humana y, particularmente, en la microbiota intestinal, lo cual evidencia su relación con el estado de salud del individuo.
La microbiota está de moda, y no solamente en el campo de la salud. Vemos ahora cómo este término ha sido incluido en las campañas de marketing de diversos productos, como alimentos, cosméticos y también medicamentos. Estamos acostumbrados a escuchar en la radio o en la televisión frases como: “cuida tu microbiota” o “sano para tu microbiota”, asegurando que el producto que ofrecen otorga mejoría de la salud en diversas áreas, como la digestiva, la de las defensas y muchas otras. En este artículo te contamos un poco más acerca de la microbiota intestinal, su composición, su función y su impacto en la salud.


18 GASTROENTEROLOGÍA
Dra. Amaya Ortiz Gastroenteróloga
Qué es la microbiota intestinal
Llamamos microbiota intestinal al conjunto de microorganismos que normalmente habita nuestro tubo digestivo, sobre todo, el intestino grueso o colon. Se calcula que la microbiota intestinal humana está compuesta por unos cien trillones de microorganismos, en su mayoría bacterias, de diversas familias, así como también algunos hongos, virus y protozoos. Estos microorganismos mantienen una relación simbiótica con la persona que los aloja, lo que significa que ambos seres se benefician de manera mutua, y constituyen un conjunto único en cada persona, como si fuera una huella dactilar.
Cómo está compuesta normalmente la microbiota intestinal
La microbiota intestinal humana está compuesta predominantemente por bacterias y, sobre todo, por dos familias principales: los bacteroides y los
firmicutes. Otras familias también presentes son las proteobacteria, verrucomicrobia, actinobacternia y fusobacteria. A su vez, dentro de cada familia existen diferentes especies, y es usual que la microbiota intestinal esté compuesta por más de 150 especies bacterianas.
La cantidad y el tipo de bacterias que encontramos en cada ser humano son únicos y pueden variar enormemente de persona a persona. Inclusive, hay variaciones en una misma persona, ya que la microbiota va modificándose a lo largo de nuestras vidas. No existe una composición específica que defina la normalidad de la microbiota intestinal y no tenemos una definición exacta de lo que sería una microbiota intestinal saludable para cada persona en su contexto particular, pero lo que sí se sabe es que la diversidad dentro de la microbiota es lo ideal.
Para qué sirve la microbiota
La microbiota participa de manera importante en la extracción, síntesis y absorción de varios nutrientes y metabolitos, como ácidos biliares, lípidos, aminoácidos, vitaminas y ácidos grasos de cadena corta. Tiene también un rol crucial para nuestras defensas, protegiéndonos de bacterias potencialmente dañinas mediante la inhibición de su crecimiento, el consumo de sus nutrientes y la producción de sustancias que atacan a estos gérmenes.
La microbiota intestinal también colabora con el mantenimiento de la integridad de la mucosa digestiva y participa en el desarrollo, regulación y función de las células de la inmunidad. Por último, hay evidencia de que la microbiota participa en la regulación del eje intestino-cerebro, por lo que tendría influencia en nuestra neurofisiología e, inclusive, en nuestro comportamiento.

GASTROENTEROLOGÍA
Cómo se conforma la microbiota intestinal
Los seres humanos adquirimos estos gérmenes desde nuestro nacimiento, y la infancia temprana es la etapa fundamental para la conformación de la microbiota intestinal. Factores que determinan su composición son la edad gestacional al nacer, el tipo de parto y el tipo de lactancia recibida. También la alimentación inicial con alimentos sólidos juega un papel importante. Así, los seres humanos contamos con una microbiota relativamente estable desde pequeños, pero que va evolucionando con nosotros, de acuerdo con nuestra edad, nuestro estilo de vida, nuestra alimentación y nuestro medioambiente, llegando así a constituir la microbiota característica de cada individuo.
Qué factores influyen en nuestra microbiota intestinal
Teniendo en cuenta que todo lo que comemos y bebemos viaja a través de nuestro tubo digestivo todos los días, es lógico que la dieta afecte a nuestra microbiota intestinal. De hecho, estudios han demostrado que un día de dieta estricta, por ejemplo, basada en productos animales o en productos vegetales, puede alterar la composición de la microbiota, de manera completamente reversible. Otro factor que puede alterar significativamente la microbiota intestinal es el uso de antibióticos. En general, se ha visto que los antibióticos disminuyen, tanto la diversidad como la cantidad de las bacterias de la microbiota intestinal, en mayor o menor medida, dependiendo del tipo de antibiótico, la dosis, el tiempo de tratamiento y el espectro del fármaco.
Por último, dos elementos que también afectan a nuestra microbiota son los probióticos y los prebióticos. Los probióticos son microorganismos vivos que, consumidos en una cantidad específica, ya sea como alimentos o suplementos, otorgan beneficios para nuestra salud; los

productos lácteos fermentados o los suplementos probióticos que contienen bacterias como lactobacillus, bifidobacterias, entre otras. Los prebióticos son productos alimenticios no digeribles que estimulan el crecimiento de las especies bacterianas beneficiosas para nuestro organismo. Diversos prebióticos están usualmente presentes en nuestra dieta, y cada uno fomenta un tipo distinto de bacteria. Por lo que, cuanto más variado comamos, mayor diversidad y cantidad de bacterias beneficiosas conseguiremos.
Cómo puede alterarse nuestra microbiota
El término utilizado para describir a una alteración de la microbiota intestinal es el de disbiosis. La disbiosis se define como un desequilibrio en microbiota intestinal y ha sido asociada con enfermedades sumamente diversas. Otro concepto también muy de moda en los últimos años es el de sobrecrecimiento bacteriano, también conocido como SIBO por sus siglas en inglés. El SIBO hace referencia a la proliferación excesiva de bacterias a nivel del intestino delgado. Se trata, por lo tanto, de un tipo de disbiosis que suele cursar con moles-
tias muy variadas, como hinchazón o distensión abdominal, diarrea, gases, entre otras.
Qué enfermedades están relacionadas con la microbiota intestinal y
con la disbiosis
El impacto de la microbiota intestinal en nuestra salud ha sido profundamente estudiado en las últimas décadas, y aún queda mucho por descubrir en este campo, pero ya se ha comprobado que alteraciones en la microbiota parecen relacionarse con diversas enfermedades, tanto del área digestiva como el de otros sistemas.
Dentro de las más estudiadas están el síndrome de intestino irritable, el hígado graso no alcohólico, la enfermedad inflamatoria intestinal, el asma, la obesidad, el cáncer, entre otras. No podemos decir que la disbiosis es la única culpable de estas patologías, pero sí parece tener un rol en su aparición, junto con otros factores.
Cómo mantener una microbiota intestinal saludable Como ya se ha mencionado, como todos tenemos una microbiota di-

20
ferente, es difícil generalizar, pero sí hay algunas consideraciones que pueden ayudarnos a evitar la disbiosis. Los probióticos y los prebióticos, presentes en nuestra dieta habitual, juegan un papel fundamental, y nuestra alimentación es probablemente el aspecto más importante a la hora de conseguir una microbiota intestinal saludable: el mejor consejo para lograr este objetivo es llevar una alimentación lo más variada posible. Además, debemos evitar el uso indiscriminado de antibióticos y tratar de realizar actividad física de manera regular, ya que también se ha demostrado que este hábito tan saludable puede modificar la micro-


biota y aumentar su diversidad. En cuanto al uso de probióticos como suplementos, tanto de manera preventiva como terapéutica, la evidencia científica es limitada y se debe valorar caso por caso, teniendo en cuenta siempre los riesgos y los beneficios en cada paciente en particular, por lo que sería conveniente consultar con un gastroenterólogo.
Como mensaje final entonces podemos decir que, en lo que respecta a cómo mantener la microbiota intestinal saludable, no existe medicamento mágico que sustituya un estilo de vida saludable.

En general, se ha visto que los antibióticos disminuyen tanto la diversidad como la cantidad de las bacterias de la microbiota intestinal.
Hipertensión arterial en niños y adolescentes

La hipertensión arterial (HTA) es una condición clínica caracterizada por un aumento sostenido de la presión arterial por encima de los valores considerados normales para la edad y talla de un niño. Es frecuentemente subdiagnosticada en pediatría, ya que muchos creen que afecta exclusivamente a los adultos.

 Dra. Leticia Gutiérrez Ferrari Cardióloga Pediátrica
Dra. Leticia Gutiérrez Ferrari Cardióloga Pediátrica
Múltiples estudios han demostrado fehacientemente que el proceso evolutivo de la hipertensión arterial tiene sus raíces en etapas tempranas de la niñez y que una intervención precoz, tanto diagnóstica como terapéutica, podría frenar este proceso y así evitar las complicaciones a mediano y largo plazo.
Mundialmente, la HTA es el principal factor de riesgo de morbimortalidad cardiovascular, afectando a más de mil millones de personas. Cerca del 50 % de estas personas no sabe que es hipertensa; y entre aquellas que
22
CARDIOLOGÍA PEDIÁTRICA
saben, sólo 1 en 5 (21 %) la tienen controlada. Su prevalencia en nuestro país se está incrementando en los últimos años, influida por factores ambientales como el sobrepeso, la ingesta de sal y alcohol o el sedentarismo. Los padres y los pediatras de atención primaria desempeñan roles decisivos e importantes en la prevención de la HTA.
Definición de HTA en niños
Se define HTA como los valores de presión arterial (PA) sistólica y diastólica igual o mayor al percentil 95, correspondiente a la edad, sexo y talla, en tres o más ocasiones. Se emplean como valores de referencia de PA los aportados en las tablas de la Task Force for Blood Pressure in Children que, para cada edad y sexo, establecen percentiles de valores de PA en relación con el percentil de talla.


CARDIOLOGÍA PEDIÁTRICA
Causas
La HTA en niños puede ser primaria o secundaria. La HTA primaria o esencial no tiene una causa identificable. Se observa en niños mayores de 10 años y generalmente con carga genética positiva. La HTA secundaria, al contrario, es cuando las cifras tensionales están elevadas como consecuencia de alguna patología primaria de base. Los pacientes suelen ser niños más pequeños con cifras tensionales muy elevadas que son rebeldes al tratamiento antihipertensivo. Las causas más comunes de hipertensión arterial secundaria son las renales (enfermedad del parénquima renal y las patologías renovasculares) y las cardiacas (coartación de aorta).
La obesidad en niños y adolescentes es también una causa frecuente de hipertensión arterial y, en la mayoría de los casos, se consigue controlar las cifras tensionales altas con el descenso de peso a través de una dieta saludable y el incremento de ejercicios físicos.

Diagnóstico

El diagnóstico de la hipertensión arterial en pediatría se basa en la medición precisa y repetida de la presión arterial, utilizando técnicas adecuadas y equipos calibrados con manguitos de tamaño adecuado para el brazo del paciente. Se recomienda que las mediciones se realicen en tres ocasiones separadas como mínimo o realizar un monitoreo ambulatorio de la presión arterial (MAPA). Es esencial hacer una historia clínica exhaustiva, indagando sobre los antecedentes patológicos personales y familiares del niño, un examen físico minucioso y llevar a cabo exámenes complementarios para detectar posibles causas subyacentes.

Recordemos que a la hipertensión arterial se le denomina “el asesino silencioso”, ya que en la mayoría de los casos no manifiesta síntomas, por lo que es de suma importancia que el pediatra tome la presión arterial en niños y adolescentes aparentemente sanos en las inspecciones médicas de
rutina.
Tratamiento de la HTA en pediatría
El manejo de la hipertensión arterial en pediatría se basa en una combinación de modificaciones en el estilo de vida y, en algunos casos, el uso de medicamentos antihipertensivos. Los cambios en el estilo de vida, para lograr el llamado “estilo de vida saludable”, incluyen una dieta balanceada, baja en sodio, alta en frutas y verduras y alimentos ricos en potasio; así como el descenso lento pero progresivo de peso en niños obesos, ya que una de las principales causas de hipertensión arterial en niños es el sobrepeso. Además, se recomien-
da fomentar la actividad física regular y evitar el sedentarismo. Estas modificaciones pueden ser suficientes en casos de hipertensión arterial de grado leve.
En casos de hipertensión arterial más severa o en presencia de alguna patología subyacente pueden ser necesarios medicamentos antihipertensivos, así como el tratamiento de la patología primaria. Es fundamental realizar un seguimiento regular para evaluar la eficacia del tratamiento y realizar ajustes si es necesario. El apoyo psicosocial también juega un rol preponderante, ya que la hipertensión arterial en pediatría puede
24
tener un impacto significativo en la calidad de vida del niño y su familia.


Conclusión
El abordaje terapéutico debe ser individualizado, considerando la gravedad de la hipertensión y la presencia o no de patologías asociadas. Los cambios en el estilo de vida, como una dieta saludable y una actividad física regular, son componentes fundamentales en el manejo de esta condición. El seguimiento continuo y la educación del niño y su familia son claves para el control a largo plazo de la hipertensión arterial en pediatría.

La hipertensión arterial en pediatría es una condición médica cada vez más prevalente y requiere una detección precoz, un diagnóstico preciso y un manejo óptimo.
REHABILITACIÓN CARDIOVASCULAR Rehabilitación cardiovascular
Las enfermedades cardiovasculares son la principal causa de mortalidad en el mundo. Cada año mueren, aproximadamente, 17,9 millones de personas debido a ella, lo que equivale a un 32 % de todas las muertes, con más del 75 % de los casos en países de bajos y medianos recursos.


Lic. Jazmín Pérez
Kinesiología y Fisioterapia

Especialista en Rehabilitación
Cardiovascular y Respiratoria
- Miembro del Plantel del Instituto
Cardiovascular del Sanatorio Migone y de CEPRECARDIO - Centro Médico de Prevención y de Rehabilitación
Cardiovascular y Respiratoria
La mitad de las muertes por enfermedad cardiovascular están relacionadas con la cardiopatía isquémica o enfermedad de las arterias coronarias del corazón (que provocan angina de pecho, infarto y/o muerte súbita), que aumentó dramáticamente de 2 millones (año 2000) a 8,9 millones (2019), representando el 16 % del total de muertes a nivel mundial. También en nuestro país ocupa el primer lugar como causante de muerte.
26
La Asociación Americana de Rehabilitación Cardiovascular y Pulmonar (American Association of Cardiovascular and Pulmonary Rehabilitation - AACVPR) define la Rehabilitación Cardiaca (RC) como un programa multifactorial y multidisciplinario para rehabilitar física, social y mentalmente a la persona que ha sufrido una enfermedad o evento (infarto, cirugía, arritmias, etc.) cardiovascular. Tiene el propósito de reintegrar al paciente a la sociedad de la mejor forma y lo más pronto posible así como evitar un nuevo evento o descompensación cardiovascular.
La Rehabilitación cardiovascular se compone de 3 fases.

• Fase I. El objetivo es ayudar al paciente a realizar actividades cotidianas, preparar a él, su familia

REHABILITACIÓN CARDIOVASCULAR
y otros allegados para una vida sana con el fin de reducir el riesgo de un evento cardiovascular (u otro nuevo), así como disminuir los trastornos emocionales y psicológicos que con frecuencia lo acompañan. En esta fase se identifican y modifican los factores de riesgo cardiovasculares.
• Fase II. El objetivo es mejorar la función cardiovascular, la capacidad de trabajo físico, la fuerza, la resistencia muscular y la flexibilidad. Además, si se detectan cambios en el electrocardiograma (ECG) o arritmias como resultado del ejercicio, se busca proporcionar una supervisión y monitoreo adecuados al paciente. Esta fase sirve, asimismo, para educación sobre las técnicas o formas de realizar el ejercicio.

• Fase III. Los objetivos se centran en seguir mejorando y mantener la forma física, así como en adquirir un compromiso de por vida por parte del paciente con la actividad física y la adquisición de un estilo de vida lo más saludable posible. Es importante que haya incorporado las técnicas, habilidades y la enseñanza necesarias para automonitorearse a sí mismo. Por supuesto, debe continuar con los objetivos de formación y conducta presentes en las fases I y II.

Entre las principales enfermedades cardiovasculares, como ya lo mencioné, la enfermedad coronaria ocupa el lugar preponderante y la que mayor derivación produce a los programas de rehabilitación.
Esta enfermedad tiene dos tipos de manejo: el tratamiento farmacológico (con o sin procedimientos invasivos como cateterismo o cirugía), que es determinado por el médico tratante; y el manejo no farmacológico, que incluye cambios en el estilo de vida, como una dieta saludable y un plan de ejercicios dentro de un Programa de Rehabilitación Cardiovascular.
La Asociación Americana del Corazón (American Heart Association - AHA) y la Sociedad Europea de Cardiología (Europe Society of Cardiology - ESC) exhortan que los Programas de Rehabilitación Cardiovascular sean mandatorios y prioritarios, que se realicen en Centros especializados (y por lo menos durante los primeros
28
3 a 6 meses posteriores a un evento cardiovascular) y que incluyan una evaluación clínica basal del individuo, asesoramiento nutricional, estrategias para el control de factores de riesgo modificables (hipertensión, diabetes, sobrepeso y obesidad, perfil lipídico y tabaquismo), indicaciones de actividad y entrenamiento físicos, así como consejería psicosocial y del sueño.


Mediante un Programa de Rehabilitación Cardiovascular adecuado se logran mejorar la capacidad funcional, la tolerancia al ejercicio y la calidad de vida de los Pacientes, e incluso disminuir el riesgo de muerte por causas cardiovasculares.
Es importante por lo tanto que el médico tratante sea el que determine los factores de riesgos y la necesidad de enviar a sus pacientes a este programa dónde, de acuerdo al perfil de riesgos encontrados, deberían realizar los ejercicios en forma supervisada y segura, contando con los recursos (humanos, de equipamiento y farmacológicos) disponibles en el Centro de Rehabilitación ante cualquier posible complicación derivada del esfuerzo intraejercicio realizado.

La Rehabilitación Cardiovascular no solo mejora la calidad de vida de las personas sino que, incluso, puede salvarles la vida.
¿Qué es la rinitis alérgica?
Las enfermedades alérgicas son frecuentes tanto en niños como en adultos, siendo en estas épocas las afecciones respiratorias alérgicas como la rinitis y el asma alérgica motivo frecuente de consulta al pediatra, clínico y a los especialistas en alergología.


 Dra. Cinthia Pérez Ortiz Alergóloga y pediatra
Dra. Cinthia Pérez Ortiz Alergóloga y pediatra

¿Qué es la rinitis alérgica?
Es una enfermedad crónica de la vía aérea superior que se caracteriza por síntomas nasales frecuentes, como estornudos, picazón de la nariz, rinorrea (secreción de la nariz) y congestión nasal que se describe como la sensación de tener la nariz tapada o bloqueada.
Cuando tenemos dos o más de estos cuatro síntomas por más de dos semanas, el diagnóstico clínico es rinitis. Si bien existen varias causas, entre ellas las infecciosas, medicamentosas u otras, la causa alérgica de la rinitis es frecuente y más aún en épocas de
30
ALERGOLOGÍA
otoño e invierno, por lo cual la rinitis alérgica de base puede verse empeorada por las infecciones virales circulantes en estas temporadas. La clasificación de la rinitis según la gravedad de los síntomas se divide en leve, moderada o severa; y según su persistencia en el tiempo, intermitente o persistente. La gravedad se caracteriza de acuerdo al grado de afectación o molestia que presenta el paciente, es decir, cuanto la calidad de vida se ve afectada por estos síntomas citados. Debido a ello, hablamos de una enfermedad que, si bien algunas personas la consideran normal en sus vidas, puede afectar el desarrollo de sus actividades cotidianas, produciendo incluso ausentismo laboral, escolar y, por momentos, incapacidad de realizar deportes o de concentrarse. Existen estudios que hablan de que las personas que padecen rinitis alérgica presentan una mayor incidencia de accidentes automovilísticos.


ALERGOLOGÍA

¿Y qué decimos del asma?
La predisposición genética familiar a desarrollar sensibilidad a alérgenos comunes es el factor predisponente identificable más fuerte para el desarrollo de asma, especialmente en niños. Otros factores gatillantes, pero que no causan la alergia, son la exposición al humo del tabaco, la contaminación del aire, las infecciones virales respiratorias en la vida temprana, ciertos medicamentos y el estrés. El asma con mayor frecuencia se inicia a temprana edad, presenta cursos variables y fenotipos inestables que pueden progresar o mejorar con el tiempo.
Para el diagnóstico de asma en niños, la historia de episodios recurrentes de sibilancias es aceptada universalmente como el punto de partida. Esto se apoya con estudios de diagnóstico como la espirometría. El número o tasa necesaria de tales episodios en general no se encuentra especificado, pero se ha propuesto un número arbitrario de tres o más. El patrón de síntomas típicos es importante para determinar el diagnóstico. Entre estos síntomas se citan los episodios recurrentes de tos, las sibilancias conocido como chillidos de pecho, la dificultad para respirar u opresión en la región torácica, que es provocada por la exposición a varios estímulos.

Las alergias se deben a una respuesta inflamatoria exagerada del organismo a alergenos inhalados (aeroalérgenos) en el caso de la rinitis y/o el asma alérgica. La respuesta inflamatoria a otros alergenos es mucho menos frecuente, como alimentos o fármacos en el caso de las afecciones respiratorias. Ante este dato, cuando tenemos síntomas respiratorios que presumimos son por alergias, los aeroalérgenos causantes más frecuentes son los ácaros del polvo doméstico, los animales como gatos y perros, los pólenes y los hongos. La percepción frecuente de alergia a los cambios climáticos se debe a que, muchas veces, ante ciertas características relacionadas con el clima, como aumento de la humedad, vientos u
otras, podría haber también un aumento de los aeroalérgenos que causan nuestras alergias y de esta forma empeoran la enfermedad de base. También, los climas fríos pueden ser gatillantes de los síntomas de alergia.
Al considerar los diferentes alérgenos inhalados, la distinción más importante es la que existe entre los alérgenos extradomiciliarios (pólenes y hongos) y los intradomiciliarios (ácaros, gatos, perros, cucarachas y hongos). Entre estos aeroalérgenos más frecuentemente implicados existe variabilidad en las distintas áreas del mundo. En un estudio hecho en nuestro país, los ácaros del polvo doméstico representaron el grupo de aeroalérgenos más prevalentes en la población infantil estudiada, dato que es similar con estudios hallados en Asia y países latinoamericanos, como Bolivia y Perú, que difiere con datos de algunas regiones europeas en los que los pólenes de gramíneas y árboles fueron los más fuertemente asociados con rinitis alérgica.
Siempre que tenemos la sospecha de una enfermedad alérgica queremos confirmar la causa de los síntomas, lo que se realiza por medio de pruebas diagnósticas, entre estas las pruebas cutáneas de alergia y
las determinaciones en sangre. Las pruebas de alergia son útiles para confirmar la causa, cuya sospecha se da tras la historia clínica, o sea, los datos que nos cuenta el paciente en la consulta. Con la prueba cutánea de alergia, método que utilizamos para el estudio del paciente alérgico, obtenemos datos beneficiosos para confirmar la sospecha diagnóstica, y elaborar un plan de tratamiento. El objetivo principal del tratamiento es el control de esta enfermedad y, para lograrlo, los pacientes, y en el caso de los niños, sus padres, deben ser educados en la gestión óptima de la enfermedad, en colaboración con sus médicos. La identificación y evitación de los desencadenantes es de gran importancia.
El diagnóstico preciso nos permite implementar terapias orientadas a la causa de la enfermedad alérgica, así como las medidas ambientales para todos los pacientes y la inmunoterapia más conocida como vacuna de alergia, en algunos casos, de acuerdo a los criterios de severidad y/o persistencia en el tiempo de los síntomas de alergia.
Otro aspecto de suma importancia, cuando hablamos de rinitis y asma, es la concomitancia muy frecuente de ambas en un mismo paciente.
32
Se debe tener en cuenta y el médico debe interrogar por los síntomas de ambas enfermedades porque en ocasiones el paciente acude a la consulta médica sólo por la afección que produce más malestar: algunas veces, los síntomas nasales y, otras, los cuadros de asma. El control de las dos patologías es de vital importancia para el buen manejo del paciente alérgico.

En la actualidad se habla del concepto de vía aérea única, y se conoce que la falta de un buen tratamiento de la rinitis alérgica puede predisponer a la falta de control del asma, así como se observó que niños con rinitis no tratada presentan mayor riesgo de desarrollar asma.
# Global Initiative for Asthma. Global Strategy for Asthma Management and Prevention [Internet]. Fontana: GINA; 2019 [citado el 26 de noviembre de 2019]. Disponible en: https://ginasthma.org/2018-gina-report-global-strategy-for-asthma-management-and-prevention/ # Brozek JL, Bousquet J, Agache I, Agarwal A, Bachert C, Bosnic-Anticevich S, et al. Allergic Rhinitis and its Impact on Asthma (ARIA) guidelines-2016 revision. J Allergy Clin Immunol. 2017;140(4):950-958. DOI: 10.1016/j.jaci.2017.03.050
# Papadopoulos NG, Arakawa H, Carlsen K-H, Custovic A, Gern J, Lemanske R, et al. International consensus on (ICON) pediatric asthma. Allergy [Internet]. 2012 Aug [cited 2019 May 19];67(8):976–97. Available from: http://www.ncbi.nlm.nih.gov/pubmed/22702533


El diagnóstico preciso nos permite implementar terapias orientadas a la causa de la enfermedad alérgica, así como las medidas ambientales para todos los pacientes.
ENDOCRINOLOGÍA PEDIÁTRICA


Pubertad precoz
La pubertad precoz es una de las patologías más frecuentes en la consulta de endocrinología pediátrica, y va en aumento debido a que está influenciada por muchos factores ambientales.

La pubertad es el periodo final del crecimiento y maduración del niño o niña en el que se alcanza la talla final y la madurez psicosocial. Es una fase en la cual se producen las modificaciones que darán lugar a las características físicas de la edad adulta y que conferirán la capacidad reproductora. Normalmente, estos cambios ocurren de forma secuencial desde la pubertad hasta alcanzar la madurez sexual. En los niños, los primeros signos de la pubertad son el aumento de tamaño de los testículos, seguido de un aumento de la longitud del pene.

34
Dra. Mónica Valdez Campuzano Endocrinóloga pediatra
A continuación comienza a aparecer el vello púbico y axilar, cambio de la voz y aumento de la musculatura. En el desarrollo fisiológico en las niñas suele aparecer, en primer lugar, el botón mamario; en segundo lugar, el vello pubiano (aunque en una de cada seis niñas aparece antes); en tercer lugar, el vello axilar y; por último, la menstruación.

La progresión de la pubertad va a acompañada de la aceleración de la velocidad de crecimiento en ambos sexos. Este crecimiento durante la pubertad no es uniforme, sufre una aceleración importante en el primer año y medio y, posteriormente, se desacelera progresivamente, dando lugar al pico o brote puberal. En los varones, la pubertad generalmente se produce entre los 9 y los 14 años y en las niñas, entre los 8 años y los 13 años.
Entonces, la pubertad precoz se define como el comienzo de la pubertad, manifestado por la aparición de
caracteres sexuales secundarios, antes de los 8 años en las niñas y antes de los 9 años en los niños. La incidencia se estima en 1/5000 y 1/10000 sujetos; situación que cada año vamos viendo con más frecuencia, sobre todo en las niñas, siendo que tienen una relación de niñas:niños de 20:1. La progresión del cuadro clínico lleva a una maduración ósea acelerada y, por tanto, a un cierre precoz de los cartílagos de crecimiento y a una talla final baja y, además, en las niñas, a la aparición temprana de la primera menstruación (menarca).
La pubertad precoz también puede causar problemas emocionales y sociales en los niños al ver que su desarrollo es diferente al de sus compañeros. Cuando la pubertad ocurre temprano puede ser simplemente una agilización del proceso normal, por lo que debemos tener en cuenta los antecedentes familiares de inicio de pubertad, sobre todo, de los padres.

ENDOCRINOLOGÍA PEDIÁTRICA

En ocasiones, la pubertad se inicia temprano debido a una anomalía en la hipófisis, o la porción del cerebro que controla a esta glándula maestra, el hipotálamo. Esta forma de pubertad precoz se denomina pubertad precoz central. Ocurre cuando el hipotálamo libera una hormona y activa la pubertad muy temprano. En la mayoría de niñas con esta entidad no existe un problema médico subyacente. En los varones, el trastorno es menos común y hay mayor probabilidad de que esté relacionado con un problema médico. Dichos problemas incluyen un tumor, traumatismo cerebral, como un golpe en la cabeza, cirugía del cerebro o tratamiento de radiación hacia la cabeza, o inflamación, como meningitis. Más raramente puede ocurrir temprano debido a que las glándulas que producen las hormonas sexuales, los ovarios en las niñas y los testículos en los niños, empiezan a funcionar por sí solas, más pronto de lo normal. Esto se denomina pubertad precoz periférica.
En ambos, los niños y las niñas, la glándula suprarrenal, la pequeña glándula que está localizada encima de los riñones, puede empezar a producir a una pronta edad hormonas masculinas llamadas andrógenos suprarrenales, causando el crecimiento del vello púbico o axilar y el olor corporal antes de cumplir los ocho años. Esta situación, llamada adrenarca, por lo general, no requiere de tratamiento, si no va acompañada de otros signos de inicio de la pubertad. Es importante mencionar que el uso de cremas o medicamentos que contienen estrógeno o andrógeno, ya sean prescritos o de venta libre, como los suplementos, pueden causar la pubertad temprana.
Se ha observado en distintos estudios realizados que en los últimos 20 años ha habido un adelanto en la edad de inicio de la pubertad, lo cual podría estar ligado con el aumento de la obesidad, sobre todo, posterior a la
pandemia del covid-19. Los mecanismos postulados para esta asociación son varios, entre los que se encuentra la mayor secreción de leptina, como consecuencia de un aumento de la grasa corporal. La leptina estimula la secreción pulsátil de gonadotrofinas, dando como consecuencia una pubertad precoz de origen central. El aumento de la grasa corporal produce un estado de hiperinsulinemia y aumentan los niveles de estrógeno, produciendo crecimiento mamario. Además, la obesidad va acompañada de reacciones inflamatorias que aumentan las citocinas y promueven la síntesis de andrógenos, llevando a un desarrollo puberal temprano.
Es importante la prevención de la obesidad en los niños mediante la promoción de estilos de vida saludable, debido a las múltiples consecuencias que puede tener sobre la salud, incluida la pubertad temprana.
No debemos olvidar a los disruptores endocrinos, los cuales son compuestos químicos exógenos, que una vez incorporados al organismo alteran la homeostasis hormonal y provocan consecuencias en el corto o largo plazo en la salud del individuo expuesto o de su descendencia, incluyendo en este grupo a la pubertad precoz. Hay más de 85 000 sustancias químicas de etiología diversa reconocidas hasta el momento y algunas de ellas han sido diseñadas para tener larga vida media, lo cual es beneficiosa para la industria pero nociva para la vida silvestre y el medioambiente, así como para la salud humana. Podemos citar a los ftalatos, plaguicidas organofosforados, bisfenol-A, PCBs, parabenos, entre muchos otros que se encuentran presentes en objetos manipulados en la vida cotidiana.
Para llegar a un diagnóstico, debemos analizar sus antecedentes médicos, además del examen físico, en

36
el cual se valora el grado de maduración puberal utilizando la escala de Tanner. Además de unos análisis de sangre para medir los niveles hormonales y una radiografía de la mano para valorar la edad ósea. En ciertos casos, el diagnóstico requiere la realización de una resonancia magnética o tomografía axial computarizada.
En caso de la pubertad precoz central, existen medicamentos para impedir que continúe el desarrollo puberal. La decisión de administrar medicamentos depende de muchos factores, incluyendo la edad del niño, la rapidez con la que progresa la pubertad, la rapidez con la que crece el niño y el pronóstico de talla final.
Los objetivos del tratamiento farmacológico consisten en permitir que el niño crezca hasta alcanzar la estatu-
ra normal de un adulto y aliviar cualquier ansiedad que sienta debido al hecho de desarrollarse antes que sus compañeros.

Si el problema es pubertad precoz periférica, el tratamiento dependerá de la causa subyacente. Puede incluir medicamentos, cirugía (si hay un tumor) o eliminación de la fuente externa de hormonas (como la crema de estrógeno).

Es importante prestar atención a cualquier signo de pubertad que pueda desarrollarse a una edad temprana, además de los controles periódicos con el pediatra, quien valorará la gráfica de crecimiento, para así ser debidamente derivados con el especialista para un tratamiento oportuno.

La pubertad precoz puede causar problemas emocionales y sociales en los niños al ver que su desarrollo es diferente al de sus compañeros.
Los trastornos de la comunicación en niños de 3 a 5 años: identificación y tratamiento temprano
La comunicación es una habilidad fundamental en el desarrollo de los niños, ya que les permite interactuar con el mundo que les rodea, expresar sus necesidades y emociones y establecer relaciones significativas. Exploraremos los trastornos de la comunicación en niños de 3 a 5 años, su identificación temprana y la importancia del tratamiento oportuno.



Los trastornos de la comunicación en niños de 3 a 5 años abarcan una amplia gama de condiciones que pueden afectar la forma en que se expresan y comprenden el lenguaje, así como su capacidad para interactuar socialmente.
Estos trastornos pueden manifestarse de diferentes maneras y presentar diversos síntomas. Es esencial detectarlos lo antes posible para brindar la intervención adecuada.
38 FONOAUDIOLOGÍA
Lic. Almudena Cino Blanes Fonoaudióloga
Algunos de los trastornos de la comunicación podrían ser:

• Trastorno del lenguaje receptivo-expresivo: presentan dificultad para comprender el lenguaje hablado y expresar sus propias ideas y pensamientos. Pueden presentar un vocabulario limitado, dificultades para seguir instrucciones y formulación de oraciones coherentes.
• Trastorno fonológico: dificultad en la pronunciación correcta de ciertos sonidos del habla. Pueden presentar omisión, sustitución o distorsión de sonidos, lo que dificulta la comprensión de su discurso por parte de los demás.
• Tartamudez: pueden presentar dificultad en el flujo del habla, lo que se manifiesta en repeticiones de sonidos, bloqueos o prolongaciones de sonidos. Esto puede afectar su fluidez y hacer que la comunicación sea frustrante.
• Trastorno específico del lenguaje (TEL): es un trastorno del desarrollo que afecta la adquisición y el uso del lenguaje en los niños. Pueden tener dificultades para comprender y utilizar el lenguaje, lo que afecta su capacidad para comunicarse de manera efectiva.

• Retraso en el desarrollo del lenguaje: el retraso en el desarrollo del lenguaje es una condición en la que el niño muestra un desarrollo más lento de las habilidades del lenguaje en comparación con otros de su misma edad cronológica. A diferencia del trastorno específico del lenguaje (TEL), el retraso en el desarrollo del lenguaje puede ser transitorio y el niño puede alcanzar niveles normales de lenguaje con el tiempo.
Es importante destacar que cada niño es único y puede presentar diferentes características y grados de severidad en los trastornos de la comunicación.
Detección temprana de los trastornos de la comunicación
Es fundamental destacar la importancia de la identificación temprana y el tratamiento oportuno de los trastornos de la comunicación en niños de 3 a 5 años. La intervención temprana puede marcar una gran diferencia en el desarrollo del lenguaje y la comunicación de un niño, mejorando su autoestima, su entorno social y su rendimiento académico. Además, abordar estos trastornos en etapas tempranas puede prevenir posibles dificultades a largo plazo y promover un desarrollo saludable en todos los aspectos de la vida del niño. A continuación se señalan algunas razones que destacan la importancia de la detección temprana de los trastornos de la comunicación y tratamiento tempranos.
Desarrollo del lenguaje: durante los primeros años de vida, el lenguaje juega un papel fundamental en el desarrollo cognitivo, social y emocional. Los trastornos de la comunicación pueden afectar la adquisición y el uso del lenguaje, lo que puede retrasar su desarrollo en estas áreas clave.
Habilidades sociales: la comunicación efectiva es fundamental para el desarrollo de habilidades sociales. Los niños que presentan dificultades para comunicarse pueden enfrentar desafíos en la interacción con su entorno. La identificación temprana y el tratamiento adecuado pueden ayudar a mejorar estas habilidades sociales y promover una mejor integración en entornos sociales. Rendimiento académico: el lenguaje es esencial para el aprendizaje escolar. Los niños con trastornos de la comunicación pueden tener dificultades para seguir instrucciones, comprender conceptos, leer y escribir. Si no se abordan adecuadamente, estas dificultades pueden afectar su rendimiento académico a largo plazo. La intervención temprana puede ayudar a superar estas barreras y brindarle las herramientas necesarias para tener éxito en su educación.
Autoestima: los niños que presen-
tan trastornos de la comunicación a menudo enfrentan frustración y dificultades para expresarse y ser comprendidos. Esto puede afectar su autoestima y bienestar emocional. La identificación temprana y el tratamiento adecuado pueden ayudar a abordar estas dificultades y promover una mayor confianza y bienestar en el niño.
Mejora a largo plazo: la plasticidad cerebral en los primeros años de vida permite que el cerebro se adapte y desarrolle nuevas conexiones neuronales. Por lo tanto, cuanto antes se identifiquen y aborden los trastornos de la comunicación, mayores serán las oportunidades de mejora y desarrollo a largo plazo.
La identificación temprana y el tratamiento oportuno de los trastornos de la comunicación en niños de 3 a 5 años son esenciales para promover un desarrollo saludable, el éxito académico y el bienestar emocional.
Evaluación fonoaudiológica
La evaluación fonoaudiológica incluirá la observación del niño en diferentes situaciones de comunicación, así como pruebas específicas para evaluar su habilidad para entender y utilizar el lenguaje. Se deben utilizar

cuestionarios o entrevistas con los padres y maestros para recopilar información adicional sobre el desarrollo del niño en diferentes situaciones. Basándose en los resultados de la evaluación, el fonoaudiólogo podrá diagnosticar el trastorno de la comunicación y desarrollar un plan de tratamiento individualizado. El tratamiento de los trastornos de la comunicación en niños de 3 a 5 años, generalmente, involucra terapia fonoaudiológica.
El fonoaudiólogo debe trabajar en estrecha colaboración con el niño para mejorar sus habilidades de comunicación, a través de actividades y ejercicios específicos. Dependiendo del trastorno específico, las sesiones de terapia pueden enfocarse en áreas como la estimulación del lenguaje, el desarrollo de habilidades de articulación, la comprensión del lenguaje o la mejora de la interacción social.
Es importante destacar que el tratamiento no se limita sólo a las sesiones con el fonoaudiólogo. Los padres y cuidadores también desempeñan un papel vital en el proceso de intervención. El fonoaudiólogo proporcionará pautas y estrategias para que los padres fomenten el desarrollo del lenguaje en el hogar y brinden un

40
FONOAUDIOLOGÍA
entorno de comunicación enriquecido.
El apoyo continuo y la práctica regular fuera de las sesiones de terapia son fundamentales para el progreso. Además de la terapia fonoaudiológica, puede ser necesario colaborar con otros profesionales de la salud, como pediatras, psicólogos u terapistas ocupacionales, dependiendo de las necesidades específicas de cada uno.

Dependiendo de la necesidad del niño se debe abordar de manera integral las dificultades de comunicación y proporcionar un plan de tratamiento completo.

Los trastornos de la comunicación en niños de 3 a 5 años requieren una atención temprana y un tratamiento oportuno.
PEDIATRÍA
Pierre Bernard Ramírez
- Avda. Mcal. López y Ulrico SchmidelClínica Villa Morra - Asunción
Telef.: 021 218 2000
GINECOLOGÍA Y OBSTETRICIA
Óscar Centurión Skoworonek
- Avda. Mcal. López c/ Guyra CampanaFdo. de la Mora
Telef.: 0981 486 850
PSIQUIATRÍA
Gabriela María Campos Cabañas
- Avda. Mcal. López y Ulrico SchmidelClínica Villa Morra - Asunción
Telef.: 021 218 2000
HEMATO ONCOLOGÍA PEDIÁTRICA
Luis Carlos de Jesús Chávez
Giménez
- Eligio Ayala N° 1293 - Sanatorio
Migone Battilana - Asunción
Telef.: 021 218 2000

La detección temprana y la intervención adecuada pueden marcar una gran diferencia en el desarrollo.
La lactancia materna: responsabilidad de todos

Además de ser uno de los alimentos más beneficiosos, es remedio, vacuna y amor. Es el mejor antídoto contra la desnutrición crónica.
La lactancia materna es la forma óptima de alimentar a los bebés, ya que proporciona los nutrientes de forma equilibrada, según la necesidad de cada bebé. La leche materna contiene además de agua, proteinas, carbohidratos, grasas, vitaminas y minerales, así como los anticuerpos y las enzimas de la madre que ejercen la función inmunológica en el principio de la vida del bebé.

 Dra. Mirtha Talavera Pediatra
Dra. Mirtha Talavera Pediatra
42 PEDIATRÍA
Los beneficios de la lactancia materna exclusiva para el bebé son varios. Desde lo emocional, permite el vínculo que le da seguridad y protección. En lo físico, la leche materna y todos sus nutrientes activan el desarrollo del organismo y reducen el riesgo de desnutrición crónica, enfermedades respiratorias, infecciones gastrointestinales, reacciones alérgicas, sobrepeso, obesidad, entre otras. La lactancia materna calma el hambre, la ansiedad y la incertidumbre, sentimientos propios de alguien que apenas está descubriendo un mundo desconocido. Los niños amamantados tienen un menor riesgo de maloclusión dental y la investigación ha demostrado que existe una relación entre la lactancia materna y mejores resultados en las pruebas de inteligencia en aquellos amamantados por más de seis meses. La lactancia materna también ayuda a mejorar la salud materna, ya que

reduce el riesgo de cáncer de mama, cáncer de ovario, hipertensión, diabetes tipo 2 y enfermedades cardiovasculares.
Es por todas estas razones que la OPS y la OMS recomiendan:

1. Que las madres y los bebés reciban apoyo para permanecer juntos y practicar el contacto piel a piel o el método de madres canguro inmediatamente luego del nacimiento y mantenerlo por lo menos una hora.
2. Ayudar a la madre a iniciar la lactancia materna dentro de la primera hora siguiente al nacimiento. Apoyarla en lo que sea necesario para que la lactancia sea exitosa.
3. Prolongar la lactancia materna exclusiva hasta los seis meses de vida y, luego, junto con alimentos complementarios nutricionalmente adecuados y seguros, hasta los dos años de edad o más.
La lactancia materna es el acto de amor que más alimenta, porque el poder de protección es para el cuerpo que está en crecimiento y para el vínculo emocional que cultiva la seguridad y la confianza que perdurarán para fortalecer el desarrollo integral del niño o niña.
Debido a esto, es fundamental que como sociedad, incluyendo el ámbito laboral y comunitario, seamos conscientes de que brindar apoyo y proporcionar consejos oportunos y actualizados a la madre y al padre durante este período de sus vidas es de suma importancia. Esto adquiere un valor trascendental en el deseo y las posibilidades de las familias de prolongarla.


Los empleadores que apoyan a sus trabajadoras para que puedan continuar amamantando a sus hijos, no sólo están tomando el camino ético, sino que además pueden estar beneficiando a sus negocios y a la economía de su país. Esto se debe a que un mayor período de lactancia se asocia con tasas más bajas de enfermedad tanto para el niño como para la ma-
dre, lo cual se traduce en un menor ausentismo laboral materno.
Este año, la Alianza Mundial pro Lactancia Materna (WABA) optó como lema de La Semana Mundial de la Lactancia Materna (1 al 7 de agosto 2023): “Facilitar la lactancia materna: marcando la diferencia para las madres y padres que trabajan”, esta se centrará en la importancia de un buen apoyo a las madres cuando se reincorporan a su trabajo remunerado, para que puedan seguir amamantando, si así lo desean, tanto tiempo como decidan.


Así, se hace un llamado a los gobiernos, empleadores, sindicatos y organizaciones de la sociedad civil
para que se cumplan las licencias de lactancia materna y exista apoyo en el lugar de trabajo, proveyendo las condiciones óptimas para que las mujeres trabajadoras amamanten y puedan seguir proveyendo su propia leche para dar continuidad a la lactancia exclusiva. Por lo que la existencia de los lactarios en los ambientes laborales es de suma importancia y utilidad.
Es muy importante que desde todos los entornos exista un compromiso a desempeñar sus respectivos roles para favorecer el empoderamiento de las familias y el mantenimiento de entornos favorables a la lactancia materna en la vida laboral.
44
PEDIATRÍA
La lactancia materna es una responsabilidad que no debe recaer sólo en la madre lactante, sino en toda sociedad.
Apoyarla, aconsejarla y acompañarla debe ser un compromiso de todos.

“Dona sangre, dona plasma, comparte la vida, compártela frecuentemente”
El mes de junio es el mes del donante de sangre, y como todos los años, el 14 de junio se celebra el Día Mundial del Donante de Sangre.
Este año, el lema de la Organización Panamericana de la Salud (OPS) y la Organización Mundial de la Salud (OMS) para la campaña del Día del Donante de Sangre es “Dona sangre, dona plasma, comparte vida, compártela frecuentemente”.
Este lema, además de incentivar la donación de sangre, también nos hace recordar que muchos pacientes necesitan transfusiones frecuentes y por mucho tiempo, lo que nos lleva a pensar en la importancia de la donación frecuente, voluntaria y no remunerada, que puede ayudar a salvar o mejorar la vida de quien la necesita.

Donar sangre, periódicamente y de forma voluntaria, es la mejor manera de asegurar el suministro seguro y sostenible de sangre y productos sanguíneos para quienes los necesiten puedan recibir tratamiento oportunamente.
Dra. Clara Moreno Hematología y hemoterapia

Cuando donás sangre, estás donando glóbulos rojos, plasma y plaquetas que son de vital importancia en algunas situaciones, ya sean de urgencia o no.
Las transfusiones de sangre y sus componentes ayudan a salvar millones de vidas al año y contribuyen a que pacientes con diferentes enfermedades vivan más tiempo y con mejor calidad de vida; además posibilitan la realización de intervenciones médicas y quirúrgicas complejas.
En la Unidad de Medicina Transfusional trabajamos para brindar la mayor seguridad, tanto a donantes como a pacientes, empezando por la selección criteriosa de donantes que, a veces, nos lleva a diferir temporal o definitivamente a algunos, para salvaguardar el bienestar de los mismos o la del eventual receptor. Toda persona sana de entre 18 y 65 años puede ser donante de sangre. Los hombres pueden donar cada tres meses y las mujeres, cada cuatro meses.
La donación voluntaria de sangre es un regalo de amor, un acto solidario y altruista por medio del cual compartimos un poco de la vida que corre por nuestras venas.
Agradecemos muy especialmente a todos los que ya son donantes de sangre e invitamos a quienes aún no lo son a que se animen a hacerlo.
46
El proceso de donación dura aproximadamente 15 minutos, no produce ningún daño al donador, no existe riesgo de contagio de enfermedades, no engorda ni adelgaza.

Capacitación médica acerca del dispositivo de asistencia ventricular ECMO CARDIOHELP



Capacitación al equipo médico y técnico del Instituto Cardiovascular del Sanatorio Migone Battilana sobre el Sistema ECMO CARDIOHELP - dispositivo de asistencia ventricular.






Este dispositivo permite soportar pacientes con patologías cardiovasculares graves, postoperatorios de cirugías cardiacas, pacientes quienes tienen estado de shock muy graves, pacientes en espera de trasplante cardiaco o de alguna intervención que pueda revertir la patología cardiovascular grave.
Cuidados y controles dentro del trabajo de parto: psicoprofilaxis obstétrica y estimulación prenatal.




Capacitación médica sobre estrategias nuevas de rehabilitación en ACV
Estrategias nuevas de rehabilitación en ACV – Disertante: Dr. Máximo Zimerman.

48
EMPRESARIALES
Capacitación de enfermería sobre cuidados y controles dentro del trabajo de parto
Semana de la Lactancia Charla presencial
Por la Semana Mundial y Nacional de la Lactancia Materna se llevó a cabo una charla presencial con el tema: ¿Qué hago cuando tengo que volver al trabajo y no quiero dejar de amamantar? Las profesionales brindaron información muy interesante, tips y recomendaciones a las mamis en periodo de lactancia y a las futuras mamis.



Los temas fueron desarrollados por profesionales de la salud: la Dra. Julia Acuña Pediatra, la Lic. Leidi Gimenez y la Lic. Patricia Naveira, ambas obstetras y asesoras de la lactancia.

Agradecemos a las marcas que apoyaron:
Conversatorio virtual: Defensa de la niñez y rendimiento escolar
Por el Mes del Niño, en el Sanatorio Migone Battilana se llevó a cabo un conversatorio virtual sobre: “Defensa de la Niñez y Rendimiento Escolar”, un tema de gran interés que influye en la salud mental y en el crecimiento de niños y adolescentes.
En el conversatorio estuvieron presentes los profesionales de la salud: la Dra. Julia Acuña, pediatra; el Dr. Nelson García, pediatra; la Lic. Patricia Espinoza, psicóloga infantil; y como invitada especial, la Dra. María Irrazábal, pediatra y Jefa del Departamento de Salud Integral de la Niñez en la Dirección de Salud Integral de la Niñez y Adolescencia (DIRSINA).



Agradecemos a las marcas que apoyaron:




49
Día del Niño












Pacientes del Sanatorio Migone





Pacientes de la Clínica Villa Morra

50
EMPRESARIALES
Día del Niño












Funcionarios




Día de la Amistad
















 Alma Teresa
José María
Farah
Alizah Valentina
Ciro
Alma Teresa
José María
Farah
Alizah Valentina
Ciro











Comida sana
Frutilla con chantilly light

La época favorita del año para sus fanáticos llegó, ¡época de frutillas!. Estamos listos para saborearla en todas sus formas: jugos, mermeladas, tartas y, sobre todo, los postres de chantilly con frutilla, pero antes no te olvides de lavarlas bien. Acá te mostramos un postre delicioso y bajo en calorías para disfrutar y a la vez cuidar la salud. ¡Lo vas a amar!
Ingredientes
• 1 pote de crema de leche light.
• 150 gramos de frutillas frescas.
• 2 cucharaditas de edulcorante en polvo: stevia o sucralosa.
Preparación
• Agregar en un recipiente o bol la crema de leche y agregar el edulcorante en polvo.

• Batir con una batidora o mixer a una velocidad baja
• Una vez que tenga la textura deseada, dejar de batir y reservar la mezcla.
• Agregar en una compotera las frutillas cortadas en trozos o enteras sin el cabito y mezclamos con la crema chantilly.

Dra. Leticia Gutiérrez Ferrari Cardióloga Pediátrica
Dra. Leticia Gutiérrez Ferrari Cardióloga Pediátrica



































 Dra. Mirtha Talavera Pediatra
Dra. Mirtha Talavera Pediatra










































































 Alma Teresa
José María
Farah
Alizah Valentina
Ciro
Alma Teresa
José María
Farah
Alizah Valentina
Ciro














